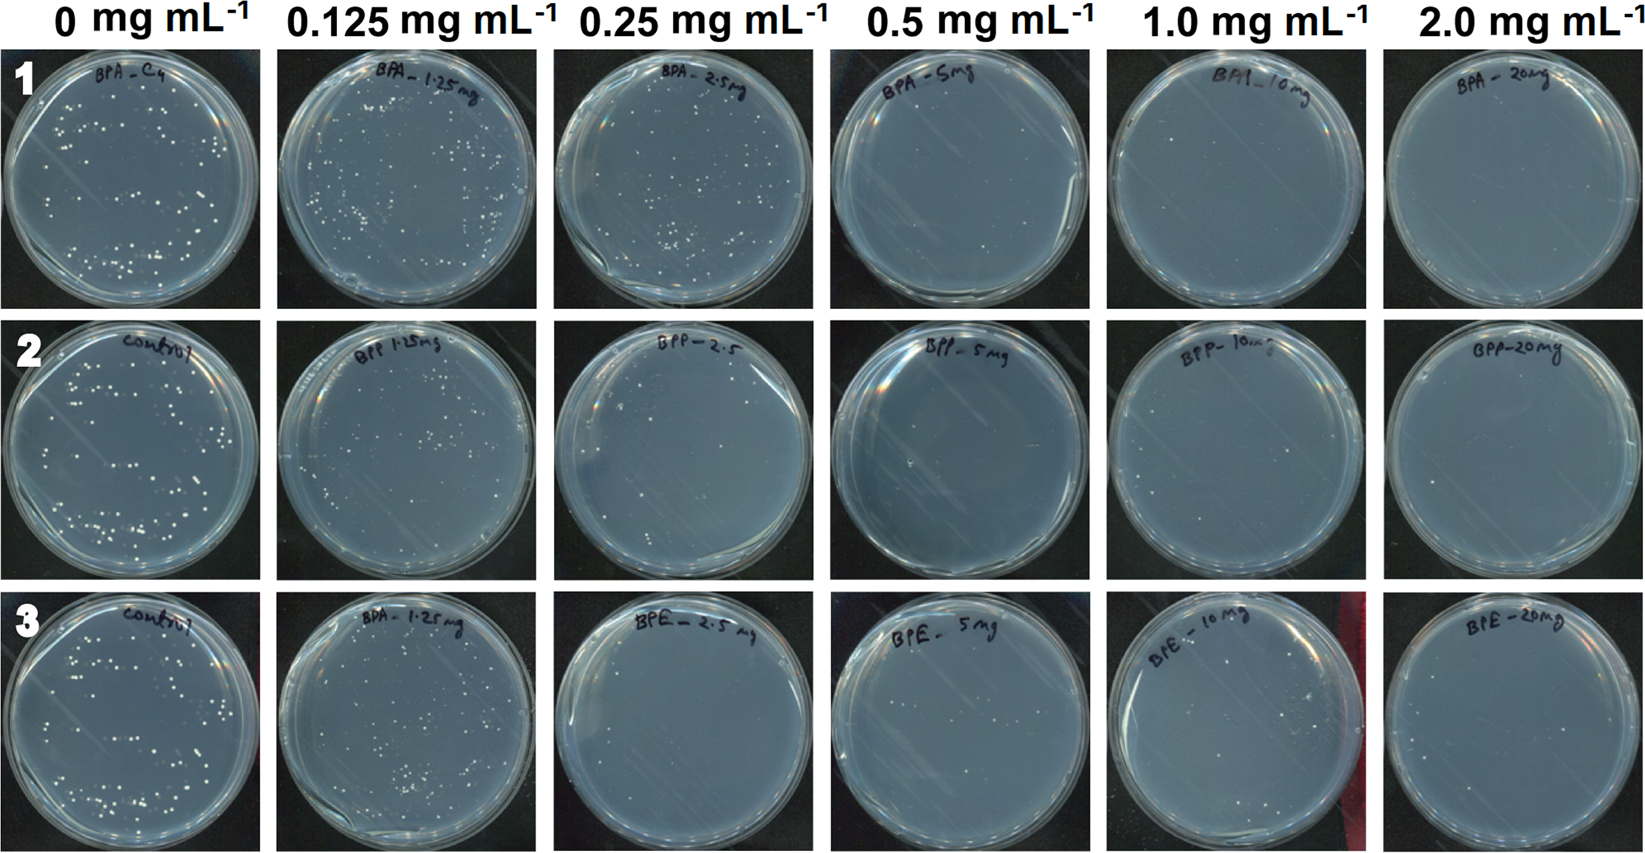
Figure 5

Figure 5

Images of C. albicans colonies on PDA plates. After treatment with different concentrations of compounds for 4 days, C. albicans cells diluted 105 times were plated on PDA.
Images of C. albicans colonies on PDA plates. After treatment with different concentrations of compounds for 4 days, C. albicans cells diluted 105 times were plated on PDA.